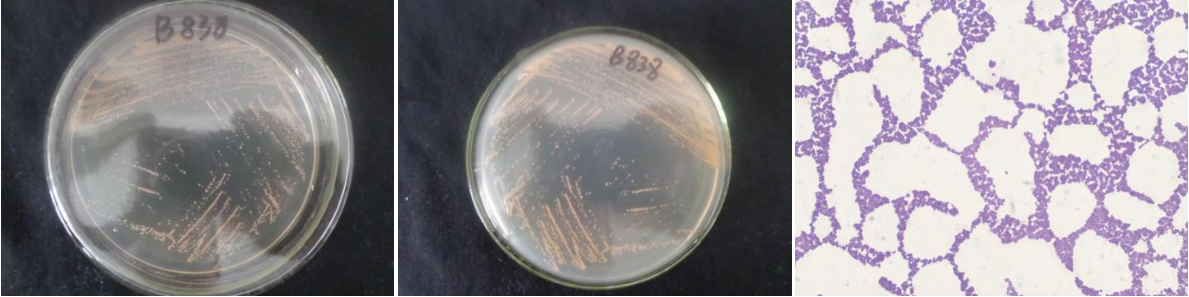

Loading...
| StrainNO | B838 |
| Classification | Arthrobacter |
| 16s rDNA sequence | GTGAGTAACCTGCCCTTAACTCTGGGATAAGCCTGGGAAACTGGGTCTAATACCGGATATGACCTTCCATCGCATGGTGGTTGG TGGAAAGCTTTTTGTGGTTTTGGATGGACTCGCGGCCTATCAGCTTGTTGGTGAGGTAATGGCTTACCAAGGCGACGACGGGTA GCCGGCCTGAGAGGGTGACCGGCCACACTGGGACTGAGACACGGCCCAGACTCCTACGGGAGGCAGCAGTGGGGAATATTGCAC AATGGGCGCAAGCCTGATGCAGCGACGCCGCGTGAGGGATGACGGCCTTCGGGTTGTAAACCTCTTTCAGTAGGGAAGAAGCGA AAGTGACGGTACCTGCAGAAGAAGCGCCGGCTAACTACGTGCCAGCAGCCGCGGTAATACGTAGGGCGCAAGCGTTATCCGGAA TTATTGGGCGTAAAGAGCTCGTAGGCGGTTTGTCGCGTCTGCCGTGAAAGTCCGGGGCTCAACTCCGGATCTGCGGTGGGTACG GGCAGACTAGAGTGATGTAGGGGAGACTGGAATTCCTGGTGTAGCGGTGAAATGCGCAGATATCAGGAGGAACACCGATGGCGA AGGCAGGTCTCTGGGCATTAACTGACGCTGAGGAGCGAAAGCATGGGGAGCGAACAGGATTAGATACCCTGGTAGTCCATGCCG TAAACGTTGGGCACTAGGTGTGGGGGACATTCCACGTTTTCCGCGCCGTAGCTAACGCATTAAGTGCCCCGCCTGGGGAGTACG GCCGCAAGGCTAAAACTCAAAGGAATTGACGGGGGCCCGCACAAGCGGCGGAGCATGCGGATTAATTCGATGCAACGCGAAGAA CCTTACCAAGGCTTGACATGAACCGGTAACGCCTGGAGACAGGTGCCCCGCTTGCGGTCGGTTTACAGGTGGTGCATGGTTGTC GTCAGCTCGTGTCGTGAGATGTTGGGTTAAGTCCCGCAACGAGCGCAACCCTCGTTCTATGTTGCCAGCACGTGATGGTGGGGA CTCATAGGAGACTGCCGGGGTCAACTCGGAGGAAGGTGGGGACGACGTCAAATCATCATGCCCCTTATGTCTTGGGCTTCACGC ATGCTACAATGGCCGGTACAAAGGGTTGCGATACTGTGAGGTGGAGCTAATCCCAAAAAGCCGGTCTCAGTTCGGATTGGGGTC TGCAACTCGACCCCATGAAGTCGGAGTCGCTAGTAATCGCAGATCAGCAACGCTGCGGTGAATACGTTCCCGGGCCTTGTACAC ACC |
| Strain Morphology Photos | |
| Morphological Description | The morphology of Colony round;orang;edge neatly;steamed bun shaped;slippy;sticky;The morphology of strain:spherical;no spore |